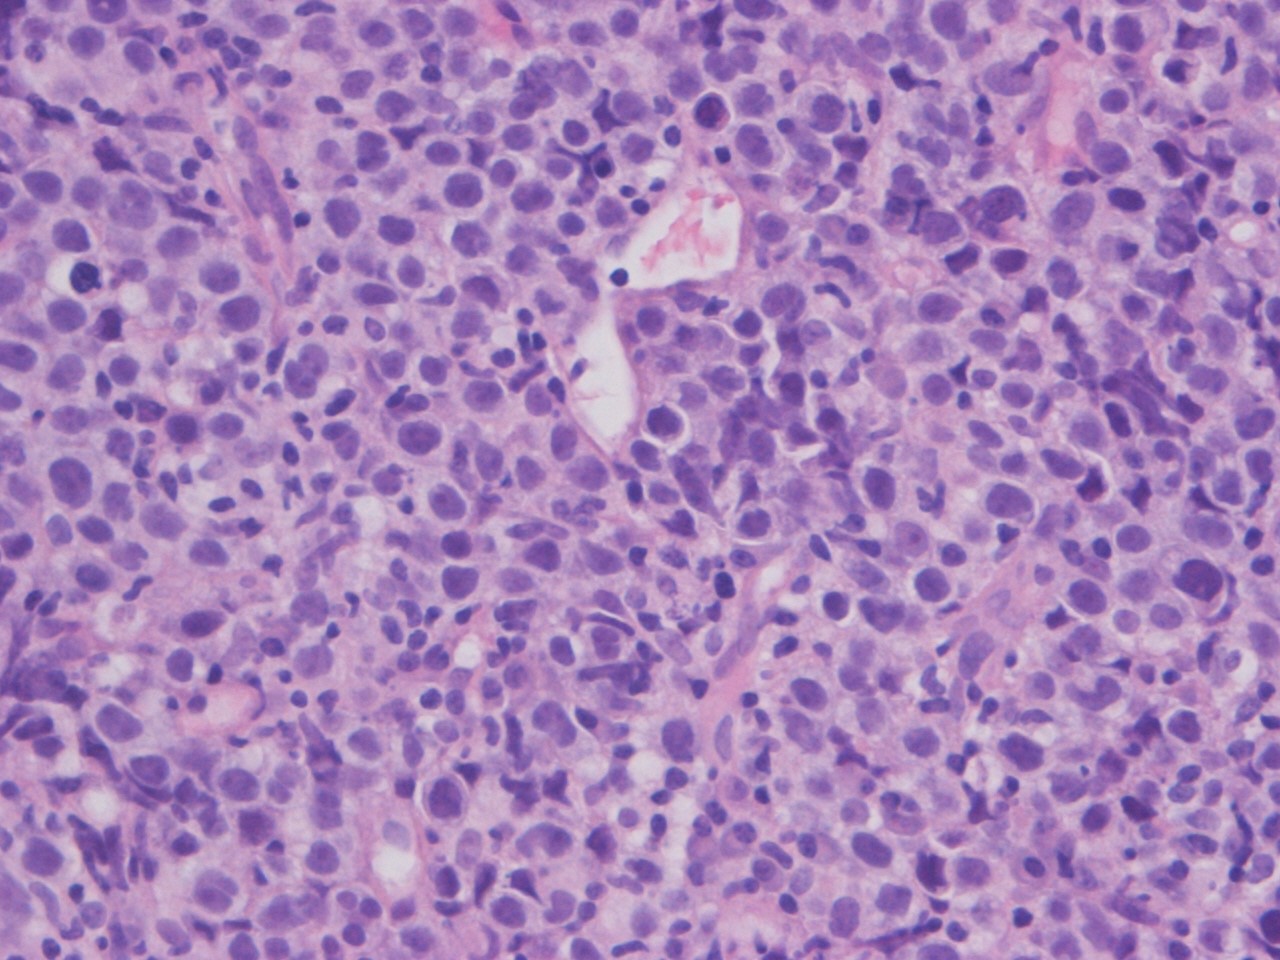
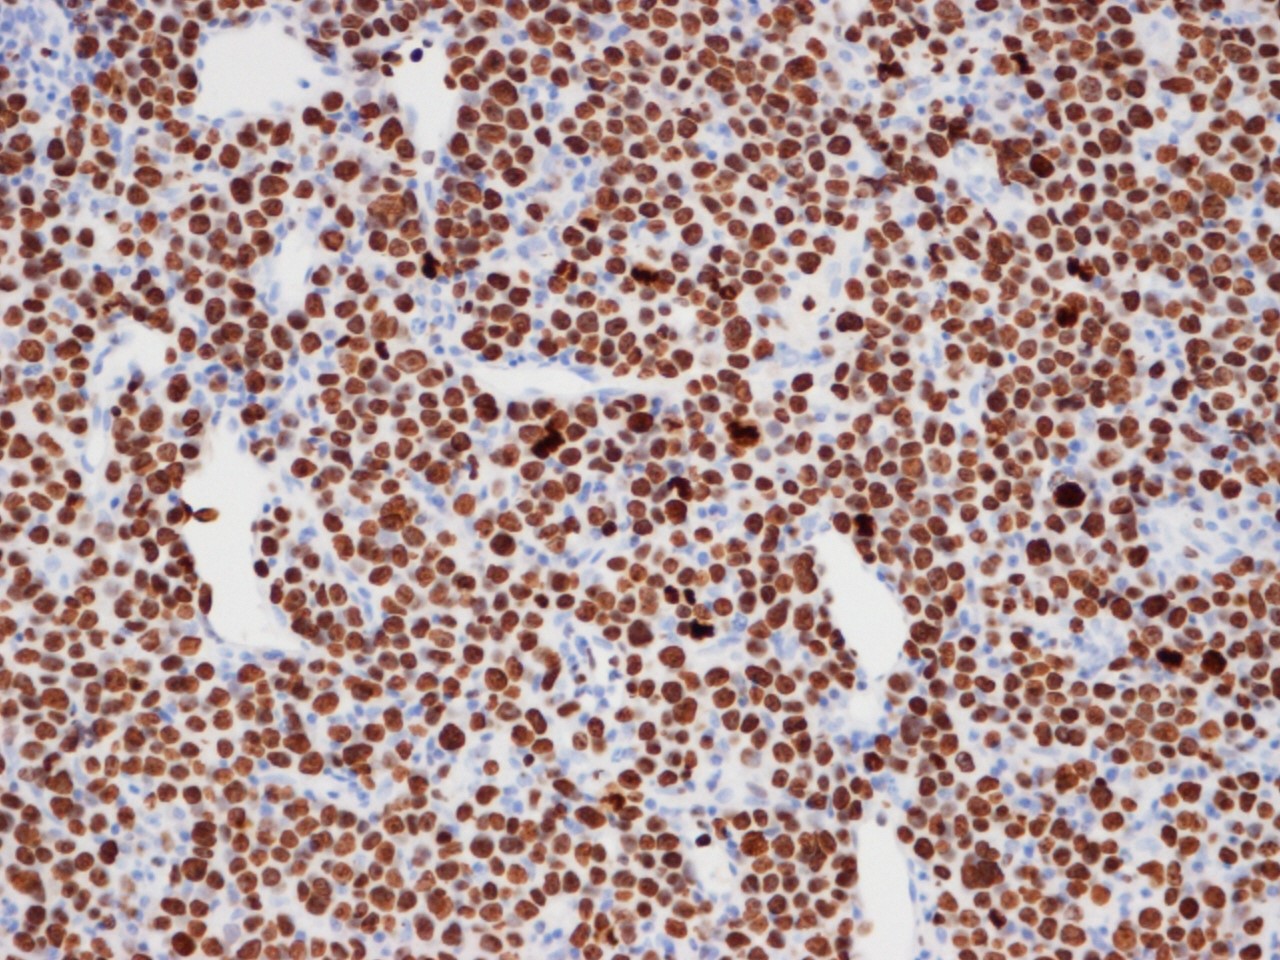

Un raro caso di linfoma cardiaco primario
Un raro caso di un linfoma cardiaco primario in un giovane immunocompetente, in cui la multidisciplinarietà del processo diagnostico ha permesso di giungere in tempi brevi all’esatta diagnosi, orientando verso la terapia specifica della malattia con rilevanti ricadute prognostiche.
Diagnostica multidisciplinare in un raro caso di linfoma cardiaco primario in un giovane immunocompetente.
Nel dicembre scorso, in occasione del congresso di Euro-Echo Imaging 2018 tenutosi in Italia, l’Unità di Cardiologia dell’Ospedale Luigi Sacco di Milano, in collaborazione con quelle di Radiologia e di Anatomia Patologica dello stesso istituto, ha presentato un raro caso di un linfoma cardiaco primario in un giovane immunocompetente, in cui la multidisciplinarietà del processo diagnostico ha permesso di giungere in tempi brevi all’esatta diagnosi, orientando verso la terapia specifica della malattia con rilevanti ricadute prognostiche.
Si definisce linfoma cardiaco primario un linfoma che coinvolge prevalentemente il cuore. Questo tumore maligno è estremamente raro in quanto rappresenta circa l'1% dei tumori cardiaci primari. Si riscontra principalmente in soggetti giovani immunodepressi o in individui di età media o avanzata.
Noi abbiamo illustrato il caso di un uomo di 23 anni che si era presentato in Pronto Soccorso lamentando da alcuni giorni una lieve dispnea e un dolore toracico. La storia clinica pregressa, l'esame obiettivo, gli esami di laboratorio, il test dell’HIV, l'elettrocardiogramma e la radiografia del torace erano risultati non significativi.
L'ecocardiogramma transtoracico (ETT) mostrava una grande massa isoecogena, non mobile, che occupava quasi interamente l'atrio destro, coinvolgeva la valvola tricuspide, che appariva funzionalmente stenotica, e si estendeva al tratto d’afflusso del ventricolo destro (Figura 1).
La tomografia computerizzata (TC) total body con contrasto mostrava all'interno del cuore destro una massa ipodensa, solida, che infiltrava le pareti del miocardio (Figura 2), circondava la radice aortica e confluiva nel mediastino superiore in una massa di linfonodi patologici fusi (Figura 3). Per il resto, la TC total body non dimostrava altri siti patologici.
La risonanza magnetica (RM) cardiaca presentava nelle sequenze cine-SSFP (Steady State Free Precession) all’interno delle camere destre una massa ipointensa, infiltrante le pareti del miocardio, il pericardio, la valvola tricuspide, la radice aortica e la vena cava superiore (Figura 4).
Le immagini DIR (Double Inversion Recovery) T1 pesate, pre- e post-contrasto, mostravano una massa isointensa che circondava, ma non invadeva, l'arteria coronaria destra (Figura 5) e un lieve enhancement precoce del gadolinio (Figura 6).
Il tumore appariva iperintenso nelle sequenze STIR (Short Time Inversion Recovery) T2 pesate (Figura 7) e presentava un lieve ed eterogeneo enhancement tardivo del gadolinio nelle immagini PSIR (Phase Sensitive) (Figura 8).
In merito alla diagnosi differenziale, i reperti ecocardiografici che suggerivano un tumore cardiaco maligno erano la posizione atriale e ventricolare destra della massa, la sua grande dimensione, la sua ampia base di impianto e il coinvolgimento della valvola tricuspide.
La TC permetteva di confermare la malignità della massa, sulla base della sua infiltrazione miocardica e pericardica. Nella fase post-contrasto una scarsa vascolarizzazione del tumore rappresentava una differenza significativa rispetto al tessuto riccamente vascolarizzato dell'angiosarcoma (che è il più frequente tumore cardiaco maligno). Inoltre, la TC evidenziava che il tumore cardiaco continuava nel mediastino superiore in una massa uniforme di linfonodi patologici con lo stesso pattern di segnale. Questo riscontro suggeriva la diagnosi di linfoma. D'altra parte, la mancanza di altre metastasi escludeva la diagnosi di angiosarcoma e di sarcomi in generale.
Infine, sulla base della RM cardiaca, la conferma dell’infiltrazione miocardica e pericardica, il rilievo della mancata infiltrazione dell'arteria coronaria destra e della scarsa vascolarizzazione, l’aspetto isointenso in T1, l’aspetto iperintenso in T2, e il lieve enhancement tardivo del gadolinio escludevano nuovamente la diagnosi di angiosarcoma, orientando al contrario verso quella di linfoma.
Dopo la diagnostica d’immagine, è stata eseguita sotto guida ETT una biopsia intramiocardica transvenosa. L'esame istologico rilevava un infiltrato di cellule di medie e grandi dimensioni con aspetto linfoide (Figura 9), positivo alla colorazione per CD20 (Figura 10) e per ki67 (Figura 11). È stato così possibile alla fine formulare una diagnosi di linfoma cardiaco primario a cellule B ad alto grado.
A completamento diagnostico, è stata effettuata la biopsia del midollo osseo che è risultata negativa.
La chemioterapia è consistita in sei cicli di R-CHOP (Rituximab - Ciclofosfamide - Adriamicina - Vincristina - Prednisolone), somministrati in un periodo di sei mesi. Durante il follow-up l’ETT (Figura 12) e la RM cardiaca senza gadolinio (Figura 13) hanno dimostrato una progressiva riduzione della massa fino al 30% della sua dimensione originale, indicando una risposta altamente significativa alla terapia e una buona prognosi.
Figura 13
Questo caso clinico, incentrato sul raro riscontro di un linfoma cardiaco primario in un giovane individuo con normale sistema immunitario, esemplifica l'importanza di un approccio d’imaging multimodale al complesso scenario delle masse intracardiache. L’ecocardiografia è una metodica non invasiva e di comune disponibilità per un’iniziale valutazione della sede, della morfologia, delle dimensioni e dell’effetto emodinamico della massa; inoltre essa guida la biopsia intramiocardica e consente il successivo controllo seriale della risposta al trattamento. La tomografia computerizzata è particolarmente utile nel processo di stadiazione, permettendo di valutare la diffusione extracardiaca della neoplasia; risulta inoltre importante nella definizione della malignità del tumore e in una prima definizione della diagnosi differenziale. La risonanza magnetica, sulla base della caratterizzazione tissutale e delle sezioni multiplane per la valutazione dell'infiltrazione cardiaca, fornisce dati essenziali ai fini della diagnosi differenziale. Tuttavia, una diagnosi definitiva si basa sull'analisi istologica.
Il Journal Club di esanum.it è un programma online di aggiornamento e discussione scientifica permanente. Se hai letto un articolo della letteratura particolarmente interessante, se hai gestito un caso clinico rilevante, se hai scritto una tesi di laurea o di specialità e vuoi condividerne i risultati, se hai metodologie o protocolli da esporre, manda il tuo materiale alla mail: articoli@esanum.it